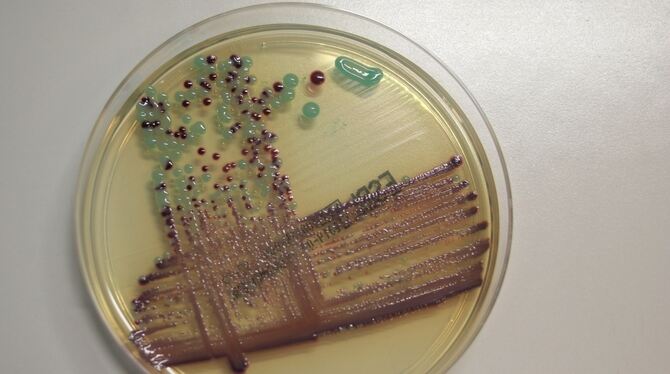

Medizin: Warnung vor »tickender Zeitbombe«
Präparat eines Escherichia coli Stammes. Escherichia coli ist ein Bakterium, das im menschlichen und tierischen Darm vorkommt. FOTO: UK
Lorem ipsum dolor sit amet, consetetur sadipscing elitr, sed diam nonumy eirmod tempor invidunt ut labore et dolore magna aliquyam erat, sed diam voluptua. At vero eos et accusam et justo duo dolores et ea rebum.
